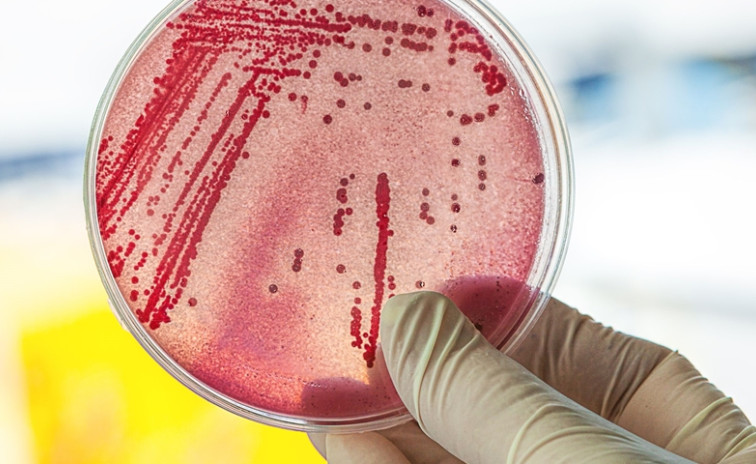

Ezen a használati tárgyon hemzseg a legtöbb baktérium, mégsem tisztítjuk soha
Ebbe még belegondolni is szörnyű.
Baktériumtenyészet
Általánosan bevett szokás, hogy legalább hetente egyszer körbenyaljuk otthonunkat, rendesen kitakarítunk, fertőtlenítünk, portalanítunk és így tovább. Amikor végzünk, azt gondoljuk, remek munkát végeztünk és most már semmilyen szennyeződés nem maradt, ami esetleg ártalmas lehet az egészségünkre - nagyobbat viszont nem is tévedhetnénk. Találd ki, mi az az egyetlen használati tárgy, amit mindennap kézbe veszel, mégsem tisztítod meg soha! Ha ennyiből nem jöttél rá, akkor a következő oldalon eláruljuk, miért lenne olyan fontos a szóban forgó objektumot is patyolatra sikálni.





























